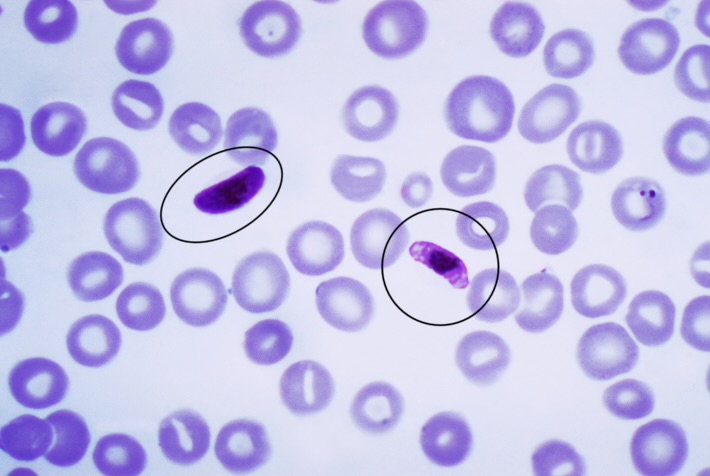
knowt flashcard image
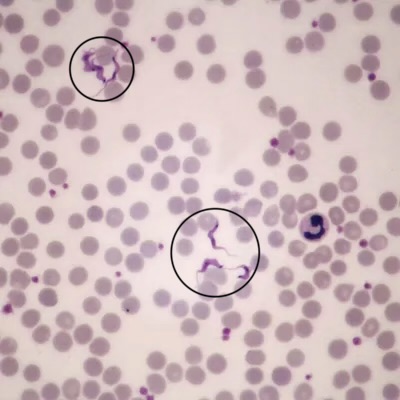
knowt flashcard image

1/16
Looks like no tags are added yet.
Name | Mastery | Learn | Test | Matching | Spaced |
|---|
No study sessions yet.
Penicillium: conidiospores and aerial hypha

Aspergillis: conidiospores and aerial hypha

Rhizopus: zygote and hypha

Rhizopus: sporangium w/ sporagiospores, aerial hypha, and columella

Saccharomyces: budding yeast w/ blastospores

Caprinus: basidium, basidiospores, central stalk

Spirogyra: water silk, coil within rectangle

Anabaena: a chain of cells that forms springs/ coil

Nostoc: chain of cells, not all uniform size or shape, like a chain of freshwater pearls

Volvox: colony form inside of individual cell

Scenedesmus: nucleus in middle w/ floating spine, was blue in lab

Paramecium: nucleus, cilia arranged on outside, oral groove

Amoeba: pseudopod and nucleus (amoeba sisters, neurons without axon)

Plasmodium blood smear: RBC and infected RBC
Trypanosoma spp. blood smear
Leishmania spp. : flagella may not be visible

Trichomonas vaginalis: undulating membrane
